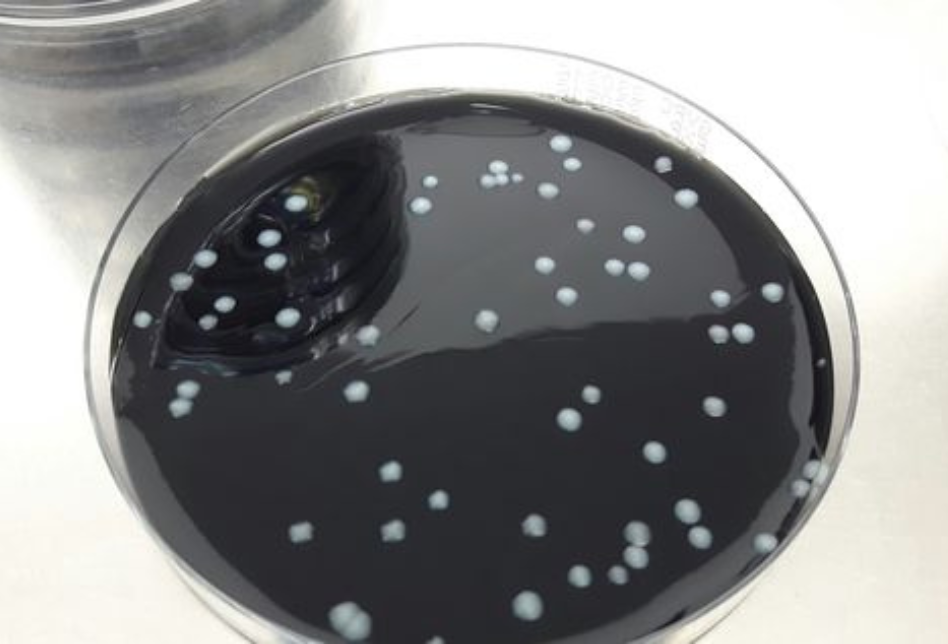

NOVEDADES DEL NUEVO REAL DECRETO 487/2022 PARA LA PREVENCIÓN Y CONTROL DE LA LEGIONELOSIS
- Se eliminan los criterios de clasificaciónde las instalaciones de riesgo en función del bajo o alto riesgo de proliferación de Legionella. Todas las instalaciones que acumulen agua y que produzcan aerosoles son consideradas de riesgo frente a la Legionella.
- Definición de responsabilidades. Se amplían las responsabilidades para el personal propio de la instalación, laboratorios de análisis, empresas de servicios externos y fabricantes de instalaciones. Se mantiene la máxima responsabilidad del cumplimiento de las obligaciones por parte del titular de la instalación.
- Se debe disponer de un Plan de Prevención y Control de Legionella (PPCL) para todas las instalaciones de riesgo. El plan debe incluir, entre otros aspectos, un diagnóstico inicial de la instalación, todos sus datos técnicos, el programa de tratamiento, el programa de muestreo y análisis del agua, y toda la documentación relacionada con la prevención de Legionellaen la instalación. Se dispone de un plazo máximo de un año, a partir de enero de 2023, para actualizar el PPCL. Alternativamente, al PPCL, el Real Decreto permite definir un Plan Sanitario frente a Legionella (PSL). Se trata de un plan de prevención que evalúa el riesgo individual y particular de cada instalación y planifica una serie de acciones de prevención, independientes al RD 487/2022, y que pueden estar basadas en las Guías Técnicas de la Organización Mundial de la Salud de Legionella y prevención de la legionelosis. El Ministerio de Sanidad indica que se trata de una opción reservada a centros sanitarios.
- Laboratorios de análisis de Legionella, La toma de muestras se llevará a cabo, bajo procedimientos documentados, que figuren siempre en el programa de muestreo, y será realizada por o bajo la responsabilidad del laboratorio que realice el ensayo mediante cultivo.
Los laboratorios que realicen los ensayos microbiológicos de Legionella y Aerobios totales, deberán estar acreditados bajo la norma UNE-EN ISO/IEC 17025:2017.
El método de referencia para la detección de Legionella spp es el método de cultivo.
Otros parámetros (hierro, conductividad, turbidez, pH, …) deben tener un sistema que asegure la calidad y ratificarlo ante una auditoria acreditada.
- Nuevas tablas que establecen frecuencias de muestreo (tabla 3), criterios de calidad del agua (tabla 1) y medidas en función de los resultados de Legionella sppdeterminados (tablas 7, 8 y 9), específicas según tipo de instalación.
Se acuerdan nuevos parámetros de análisis, aerobios totales, hierro, turbidez, … y nuevas frecuencias, se cuadriplica las muestras de análisis de Legionella en agua potable y torres de refrigeración; en jacuzzis se duplican las muestras.
En la tabla que se adjunta se determinan las frecuencias a llevar a cabo:

- Nuevos protocolos de toma de muestras, detallando condiciones de conservación y transporte de las muestras, características de los envases y procedimientos en función de la instalación y el análisis realizado.
- Programa de muestreo y análisis de agua (Legionella y otros), en cada muestreo se recogerá muestra del agua como mínimo de los siguientes puntos:
- a) Un punto en el depósito.
- b) Un punto en el acumulador.
- c) Un punto en el circuito de retorno.
- d) Dos puntos medios de la instalación.
- e) Cada uno de los puntos terminales identificados.
- Se modifican los requisitos de formación para todo el personal involucrado en el PPCL.
El personal propio de la empresa titular de las instalaciones o de empresas de servicios a terceros que realice acciones menores (como controles de temperatura, pH o biocida) deberá ser incluida en un plan de formación específico.
El personal implicado en el PPCL deberá dar cumplimiento a lo establecido en el Real Decreto 830/2010, de 25 de junio, por el que se establece la normativa reguladora de la capacitación para realizar tratamientos con biocidas.
Para el caso del responsable técnico se deberá disponer de una titulación universitaria del área científica o de un certificado de profesionalidad específico. Para el caso del resto de personal que desempeñe su actividad relativa al programa de tratamiento PPCL se deberá disponer de un certificado de profesionalidad específico de la cualificación profesional SEA 492-2 “mantenimiento higiénico-sanitario de instalaciones susceptibles de profileración de micoorganismos nocivos y Legionella y su diseminación por aerosolización”.
Por otra parte, se establece una prórroga de 5 años en la validez de los certificados de aprovechamiento recogidos en la Orden SCO/317/2003.
- En los procesos de limpieza y desinfección se exige aumentar las frecuencias de estos, en el caso de acumuladores de ACS se debe realizar trimestralmente; en el caso de piscinas se debe vaciar el vaso, lo que supone unos protocolos de limpieza con más vertidos de agua.